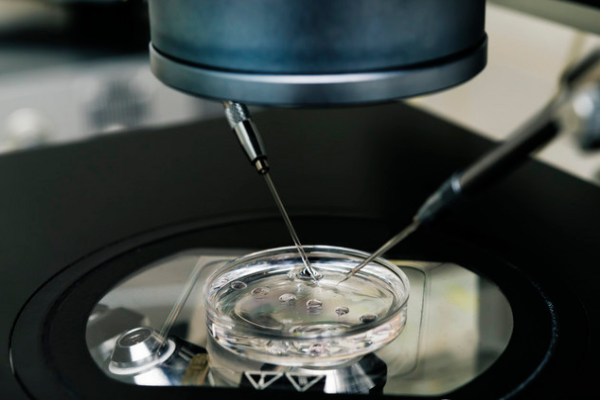
eb38e02fcc1aa4987e09f4a167fed88a.png 试管婴儿失败后要做些什么

试管婴儿失败后要做些什么?做好这5点,助力下次成功!
随着不孕不育人群的增多,越来越多的人也接触并运用了试管婴儿技术,以此来帮助自己成功好孕。但在实际接触试管婴儿技术后,能够发现做试管婴儿成功率并不是100%的,有一些患者第一次做了试管后可能是失败的。这无疑会对患者造成较大的打击,不知道怎么办才好。对此,我们来看看试管婴儿失败后要做些什么吧。
一、给自己放个假
试管期间,要经历吃药、打针、促排、取卵、胚胎移植等等,不管是身体还是心理,一直处于一个高度紧张的状态。很多病人来找问诊时,肚皮上还有淤青和针孔。尤其不建议大家连续取卵,持续的药物刺激和心理压力对于卵泡质量不起好作用不说,很多一次不如一次。
建议大家利用春节前后给自己放个假,暂时不想备孕的事情,把身体养好,保持心情愉悦放松。每一个努力备孕的女性都不容易。
二、查原因
把备孕的事情放下之后,可以带着以前的结果和检查单去找一些妇产科的专家看看失败的原因是什么?很多试管机构失败之后不说原因,门诊上都是从头到尾看一遍检查单,逐个分析原因,看是因为内膜原因不着床?还是卵泡质量不好?或者是激素水平不稳定?找到问题再去解决,才能从根本上提高成功率。
失败之后不用着急去做更多的检查,一般来说试管期间做的检查都是非常全面了,可以先找专业医生看检查单,根据建议再做补充检查。试管本身花费就比较多,能省的检查就省下来。
三、中药调理
中医门诊上越来越多试管失败的人来调理,对于女性内分泌和身体调理确实有优势中医强调气血平衡对于生殖健康的重要性,试管前调理体质,帮助准孕妈尽快恢复元气,把体质调到适合怀孕的状态是很有必要的。
四、适当的补充一些营养和运动
试管结束后,身体处于一个急需补养的阶段,不管是出于未来备孕还是身体健康的角度,可以适当吃一些叶酸、维生素c帮助身体恢复。当然这些不要自行在家吃,根据医生要求,每个人情况不一样,吃之前先咨询医生,根据身体情况选定。

可以在非经期进行一些动作比较迟缓的运动,比如说太极、瑜伽、保健操等等,容易坚持,也给身体一个活力。有巧克力囊肿的女性一定要注意避免剧烈运动,比如说跳绳之类的,避免发生囊肿扭转或者破裂。
五、养成睡前泡脚的习惯
由于身体或者或者焦虑,很多备孕女性睡眠质量不太好,入睡困难还多梦。可以用中药煮水泡脚,一来温暖身体祛除湿气,二来放松心情提前进入睡眠状态。

做试管婴儿失败并不是一件可怕的事情,很多试管夫妇会在失败后一蹶不振,这是不可取的。试管夫妇一定要好好的调理自己的心态,让自己接受这一结果,然后再按照上述5点做好对应的准备,为下一次做试管婴儿打下坚实的基础。进而让自己以最好的、最合适的状态做试管婴儿。